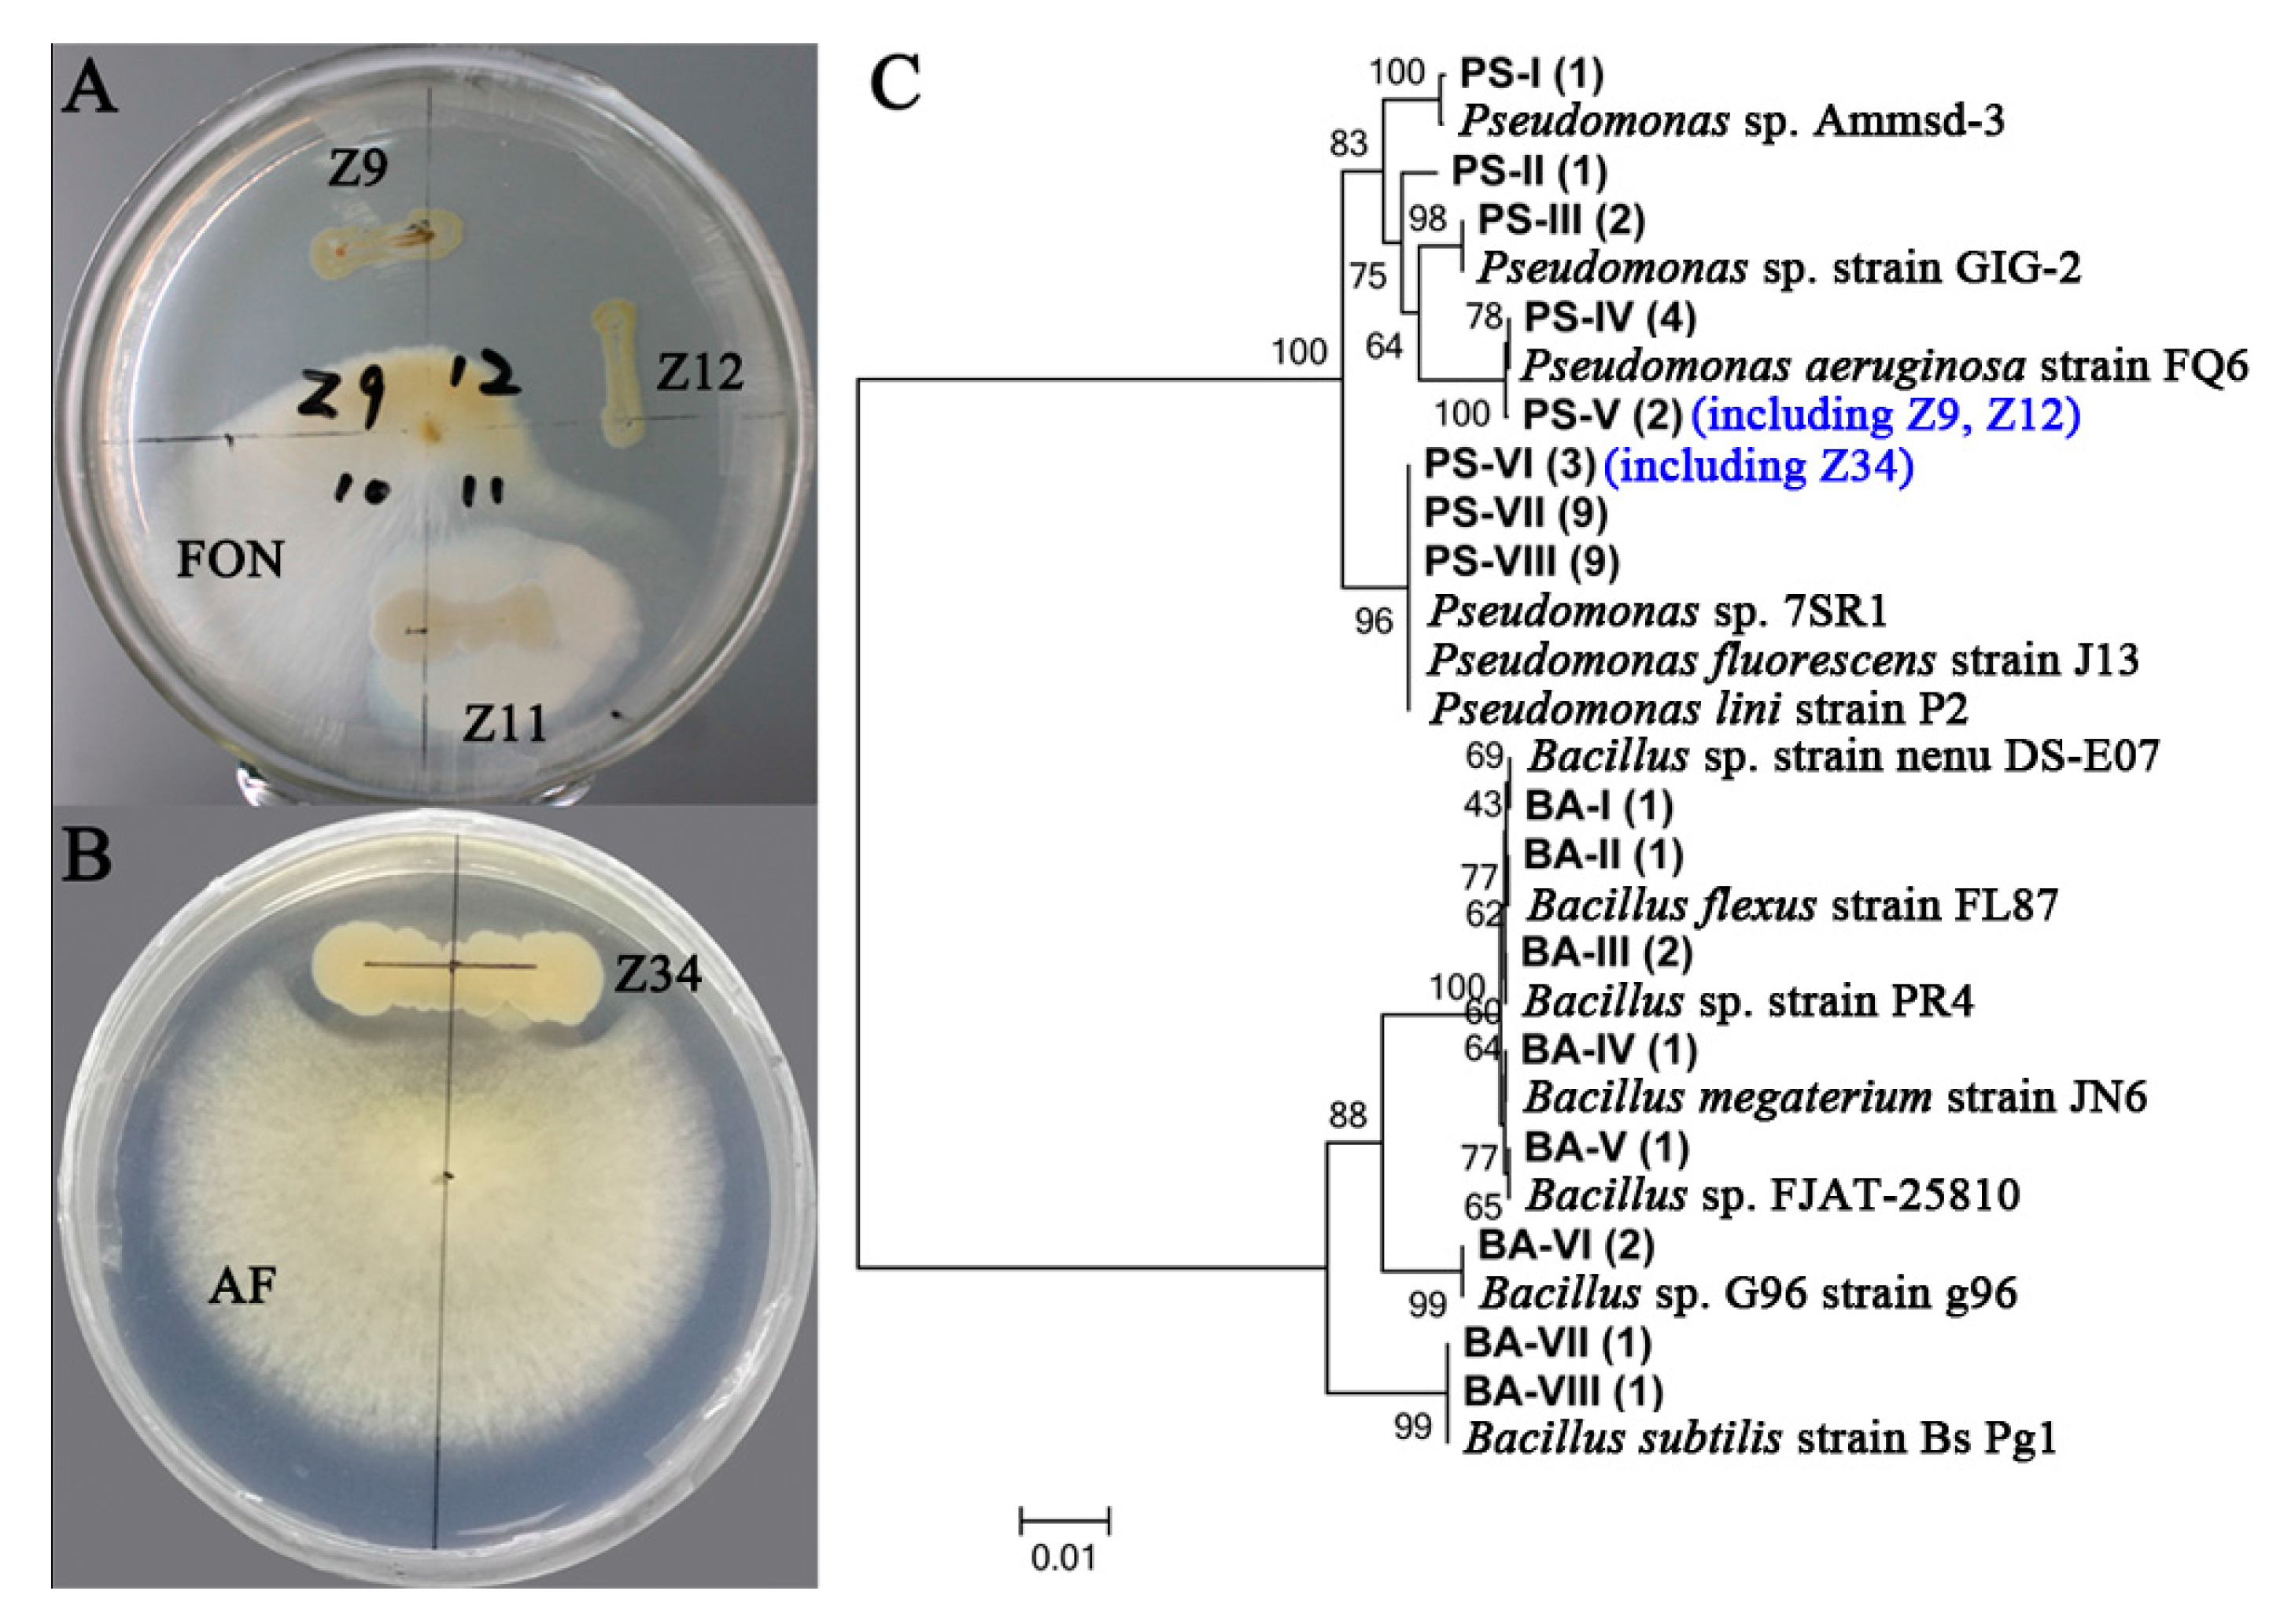
Ijms 19 00850 g005 Ijms 19 00850 g005

Barcoded Pyrosequencing Reveals a Shift in the Bacterial Community in the Rhizosphere and Rhizoplane of Rehmannia glutinosa under Consecutive Monoculture
Abstract
1. Introduction
2. Results
2.1. Operational Taxonomic Unit (OTU) Cluster and Species Annotation
2.2. Alpha Diversity Analysis
2.3. Beta Diversity Analysis
2.4. Venn Diagram and Similarity Analysis
2.5. Shifts in Soil Bacterial Community Structure under Consecutive Monoculture
2.6. Isolation of Pseudomonas and Bacillus and Their Antagonistic Activities Assessment
3. Discussion
4. Materials and Methods
4.1. Field Experiment and Soil Sampling
4.2. Soil DNA Extraction and PCR Amplification
4.3. Library Preparation and Illumina Sequencing
4.4. Operational Taxonomic Unit (OTU) Cluster and Species Annotation
4.5. Alpha Diversity and Beta Diversity Analyses
4.6. Statistical Analyses of Pyrosequencing Data
4.7. Isolation of Pseudomonas spp. and Bacillus spp. and Their Antagonistic Activities Assessment
5. Conclusions
Supplementary Materials
Acknowledgments
Author Contributions
Conflicts of Interest
Abbreviations
| T-RFLP | terminal restriction fragment length polymorphism |
| PLFA | phospholipid fatty acid |
| OTU | operational taxonomic unit |
| NPR | rhizosphere soil from the newly planted plants |
| MUR | rhizosphere soil from monocultured uninfected plants |
| MIR | rhizosphere soil from monocultured infected plants |
| NPP | rhizoplane soil from the newly planted plants |
| MUP | rhizoplane soil from monocultured uninfected plants |
| MIP | rhizoplane soil from monocultured infected plants |
| PCoA | principal coordinate analysis |
| UPGMA | unweighted pair-group method with arithmetic means |
| WUF | weighted UniFrac metric |
| UUF | unweighted UniFrac metric |
| NMDS | non-metric multidimensional scaling |
| ANOVA | one-way analysis of variance |
| ANOSIM | analysis of similarity |
| LDA | linear discriminant analysis |
| LEfSe | linear discriminant analysis effect size |
| PDA | potato-dextrose agar |
References
- Park, S.U.; Park, N.I.; Kim, Y.K.; Suh, S.Y.; Eom, S.H.; Lee, S.Y. Application of plant biotechnology in the medicinal plant, Rehmannia glutinosa Liboschitz. J. Med. Plants Res. 2009, 3, 1258–1263. [Google Scholar]
- Wu, L.K.; Wang, J.Y.; Huang, W.M.; Wu, H.M.; Chen, J.; Yang, Y.Q.; Zhang, Z.Y.; Lin, W.X. Plant-microbe rhizosphere interactions mediated by Rehmannia glutinosa root exudates under consecutive monoculture. Sci. Rep. 2015, 5, 15871. [Google Scholar] [CrossRef] [PubMed]
- Wu, L.K.; Wu, H.M.; Chen, J.; Wang, J.Y.; Lin, W.X. Microbial community structure and its temporal changes in Rehmannia glutinosa rhizospheric soils monocultured for different years. Eur. J. Soil Biol. 2016, 72, 1–5. [Google Scholar] [CrossRef]
- Yang, Y.H.; Chen, X.; Chen, J.; Xu, H.; Li, J.; Zhang, Z. Differential miRNA expression in Rehmannia glutinosa plants subjected to continuous cropping. BMC Plant Biol. 2011, 11, 53. [Google Scholar] [CrossRef] [PubMed]
- Li, Z.F.; Yang, Y.Q.; Xie, D.F.; Zhu, L.F.; Zhang, Z.G.; Lin, W.X. Identification of autotoxic compounds in fibrous roots of Rehmannia (Rehmannia glutinosa Libosch). PLoS ONE 2012, 7, e28806. [Google Scholar] [CrossRef] [PubMed]
- Huang, L.F.; Song, L.X.; Xia, X.J.; Mao, W.H.; Shi, K.; Zhou, Y.H.; Yu, J.Q. Plant-soil feedbacks and soil sickness: From mechanisms to application in agriculture. J. Chem. Ecol. 2013, 39, 232–242. [Google Scholar] [CrossRef] [PubMed]
- Wu, L.K.; Li, Z.F.; Li, J.; Khan, M.A.; Huang, W.M.; Zhang, Z.Y.; Lin, W.X. Assessment of shifts in microbial community structure and catabolic diversity in response to Rehmannia glutinosa monoculture. Appl. Soil Ecol. 2013, 67, 1–9. [Google Scholar] [CrossRef]
- Bouhaouel, I.; Gfeller, A.; Fauconnier, M.L.; Rezgui, S.; Amara, H.S.; Du Jardin, P. Allelopathic and autotoxicity effects of barley (Hordeum vulgare L. ssp. vulgare) root exudates. BioControl 2015, 60, 425–436. [Google Scholar] [CrossRef]
- Ren, X.; He, X.; Zhang, Z.; Yan, Z.; Jin, H.; Li, X.; Qin, B. Isolation, identification, and autotoxicity effect of allelochemicals from rhizosphere soils of flue-cured tobacco. J. Agric. Food Chem. 2015, 63, 8975–8980. [Google Scholar] [CrossRef] [PubMed]
- Li, X.G.; Ding, C.F.; Hua, K.; Zhang, T.L.; Zhang, Y.N.; Zhao, L.; Yang, Y.R.; Liu, J.G.; Wang, X.X. Soil sickness of peanuts is attributable to modifications in soil microbes induced by peanut root exudates rather than to direct allelopathy. Soil Biol. Biochem. 2014, 78, 149–159. [Google Scholar] [CrossRef]
- Arafat, Y.; Wei, X.; Jiang, Y.; Chen, T.; Saqib, H.S.A.; Lin, S.; Lin, W. Spatial distribution patterns of root-associated bacterial communities mediated by root exudates in different aged ratooning tea monoculture systems. Int. J. Mol. Sci. 2017, 18, 1727. [Google Scholar] [CrossRef] [PubMed]
- Zhou, X.; Wu, F. p-Coumaric acid influenced cucumber rhizosphere soil microbial communities and the growth of Fusarium oxysporum f. sp. cucumerinum Owen. PLoS ONE 2012, 7, e48288. [Google Scholar]
- Mazzola, M.; Manici, L.M. Apple replant disease: Role of microbial ecology in cause and control. Annu. Rev. Phytopathol. 2012, 50, 45–65. [Google Scholar] [CrossRef] [PubMed]
- Wu, H.M.; Wu, L.K.; Zhu, Q.; Wang, J.Y.; Qin, X.J.; Xu, J.H.; Kong, L.; Chen, J.; Lin, S.; Khan, M.U.; et al. The role of organic acids on microbial deterioration in the Radix pseudostellariae rhizosphere under continuous monoculture regimes. Sci. Rep. 2017, 7, 3497. [Google Scholar] [CrossRef] [PubMed]
- Hirsch, P.R.; Mauchline, T.H.; Clark, I.M. Culture-independent molecular techniques for soil microbial ecology. Soil Biol. Biochem. 2010, 42, 878–887. [Google Scholar] [CrossRef]
- Saleem, M.; Law, A.D.; Moe, L.A. Nicotiana roots recruit rare rhizosphere taxa as major root-inhabiting microbes. Microb. Ecol. 2016, 71, 469–472. [Google Scholar] [CrossRef] [PubMed]
- Roh, S.W.; Abell, G.C.; Kim, K.H.; Nam, Y.D.; Bae, J.W. Comparing microarrays and next-generation sequencing technologies for microbial ecology research. Trends Biotechnol. 2010, 28, 291–299. [Google Scholar] [CrossRef] [PubMed]
- Yang, Q.; Wang, R.; Xu, Y.; Kang, C.; Miao, Y.; Li, M. Dynamic change of the rhizosphere microbial community in response to growth stages of consecutively monocultured Rehmanniae glutinosa. Biologia 2016, 71, 1320–1329. [Google Scholar] [CrossRef]
- Edwards, J.; Johnson, C.; Santos-Medellín, C.; Lurie, E.; Podishetty, N.K.; Bhatnagar, S.; Eisen, J.A.; Sundaresan, V. Structure, variation, and assembly of the root-associated microbiomes of rice. Proc. Natl. Acad. Sci. USA 2015, 112, E911–E920. [Google Scholar] [CrossRef] [PubMed]
- Saleem, M.; Law, A.D.; Sahib, M.R.; Pervaiz, Z.H.; Zhang, Q.M. Impact of root system architecture on rhizosphere and root microbiome. Rhizosphere 2018, 6, 47–51. [Google Scholar] [CrossRef]
- Liu, J.; Li, X.; Jia, Z.; Zhang, T.; Wang, X. Effect of benzoic acid on soil microbial communities associated with soilborne peanut diseases. Appl. Soil Ecol. 2017, 110, 34–42. [Google Scholar] [CrossRef]
- Berendsen, R.L.; Pieterse, C.M.; Bakker, P.A. The rhizosphere microbiome and plant health. Trends Plant Sci. 2012, 17, 478–486. [Google Scholar] [CrossRef] [PubMed]
- Berg, G.; Köberl, M.; Rybakova, D.; Müller, H.; Grosch, R.; Smalla, K. Plant microbial diversity is suggested as the key to future biocontrol and health trends. FEMS Microbiol. Ecol. 2017, 93, fix050. [Google Scholar] [CrossRef] [PubMed]
- Raaijmakers, J.M.; Paulitz, T.C.; Steinberg, C.; Alabouvette, C.; Moënne-Loccoz, Y. The rhizosphere: A playground and battlefield for soilborne pathogens and beneficial microorganisms. Plant Soil 2009, 321, 341–361. [Google Scholar] [CrossRef]
- Van Bruggen, A.H.; Narouei-Khandan, H.A.; Gravel, V.; Blok, W.J. Corky root severity, root knot nematode galling and microbial communities in soil, rhizosphere and rhizoplane in organic and conventional greenhouse compartments. Appl. Soil Ecol. 2016, 100, 112–123. [Google Scholar] [CrossRef]
- Chaparro, J.M.; Sheflin, A.M.; Manter, D.K.; Vivanco, J.M. Manipulating the soil microbiome to increase soil health and plant fertility. Biol. Fert. Soils 2012, 48, 489–499. [Google Scholar] [CrossRef]
- Liu, X.; Zhang, J.; Gu, T.; Zhang, W.; Shen, Q.; Yin, S.; Qiu, H. Microbial community diversities and taxa abundances in soils along a seven-year gradient of potato monoculture using high throughput pyrosequencing approach. PLoS ONE 2014, 9, e86610. [Google Scholar] [CrossRef] [PubMed]
- Xiong, W.; Li, R.; Ren, Y.; Liu, C.; Zhao, Q.; Wu, H.; Jousset, A.; Shen, Q.R. Distinct roles for soil fungal and bacterial communities associated with the suppression of vanilla Fusarium wilt disease. Soil Biol. Biochem. 2017, 107, 198–207. [Google Scholar] [CrossRef]
- Bennett, A.J.; Bending, G.D.; Chandler, D.; Hilton, S.; Mills, P. Meeting the demand for crop production: The challenge of yield decline in crops grown in short rotations. Biol. Rev. 2012, 87, 52–71. [Google Scholar] [CrossRef] [PubMed]
- Lakshmanan, V.; Selvaraj, G.; Bais, H.P. Functional soil microbiome: Belowground solutions to an aboveground problem. Plant Physiol. 2014, 166, 689–700. [Google Scholar] [CrossRef] [PubMed]
- Mendes, R.; Kruijt, M.; de Bruijn, I.; Dekkers, E.; van der Voort, M.; Schneider, J.H.; Piceno, Y.M.; DeSantis, T.Z.; Andersen, G.L.; Bakker, P.A.; et al. Deciphering the rhizosphere microbiome for disease-suppressive bacteria. Science 2011, 332, 1097–1100. [Google Scholar] [CrossRef] [PubMed]
- Xue, C.; Penton, C.R.; Shen, Z.; Zhang, R.; Huang, Q.; Li, R.; Ruan, Y.; Shen, Q. Manipulating the banana rhizosphere microbiome for biological control of Panama disease. Sci. Rep. 2015, 5, 11124. [Google Scholar] [CrossRef] [PubMed]
- Aleti, G.; Nikolić, B.; Brader, G.; Pandey, R.V.; Antonielli, L.; Pfeiffer, S.; Oswald, A.; Sessitsch, A. Secondary metabolite genes encoded by potato rhizosphere microbiomes in the Andean highlands are diverse and vary with sampling site and vegetation stage. Sci. Rep. 2017, 7, 2330. [Google Scholar] [CrossRef] [PubMed]
- Wu, K.; Yuan, S.; Wang, L.; Shi, J.; Zhao, J.; Shen, B.; Shen, Q. Effects of bio-organic fertilizer plus soil amendment on the control of tobacco bacterial wilt and composition of soil bacterial communities. Biol. Fert. Soils 2014, 50, 961–971. [Google Scholar] [CrossRef]
- Vida, C.; Bonilla, N.; de Vicente, A.; Cazorla, F.M. Microbial profiling of a suppressiveness-induced agricultural soil amended with composted almond shells. Front. Microbiol. 2016, 7, 4. [Google Scholar] [CrossRef] [PubMed]
- Li, X.; Zhang, Y.N.; Ding, C.; Jia, Z.; He, Z.; Zhang, T.; Wang, X.X. Declined soil suppressiveness to Fusarium oxysporum by rhizosphere microflora of cotton in soil sickness. Biol. Fert. Soils 2015, 51, 935. [Google Scholar] [CrossRef]
- Beier, S.; Bertilsson, S. Bacterial chitin degradation-mechanisms and ecophysiological strategies. Front. Microbiol. 2013, 4, 149. [Google Scholar] [CrossRef] [PubMed]
- Chapelle, E.; Mendes, R.; Bakker, P.A.H.; Raaijmakers, J.M. Fungal invasion of the rhizosphere microbiome. ISME J. 2016, 10, 265–268. [Google Scholar] [CrossRef] [PubMed]
- Tan, Y.; Cui, Y.; Li, H.; Kuang, A.; Li, X.; Wei, Y.; Ji, X. Diversity and composition of rhizospheric soil and root endogenous bacteria in Panax notoginseng during continuous cropping practices. J. Basic Microb. 2017, 57, 337–344. [Google Scholar] [CrossRef] [PubMed]
- Li, T.; Liu, T.; Zheng, C.; Kang, C.; Yang, Z.; Yao, X.; Song, F.; Zhang, R.; Wang, X.; Xu, N.; et al. Changes in soil bacterial community structure as a result of incorporation of Brassica plants compared with continuous planting eggplant and chemical disinfection in greenhouses. PLoS ONE 2017, 12, e0173923. [Google Scholar] [CrossRef] [PubMed]
- Zhang, Z.; Yuen, G.Y.; Sarath, G.; Penheiter, A.R. Chitinases from the plant disease biocontrol agent, Stenotrophomonas maltophilia C3. Phytopathology 2001, 91, 204–211. [Google Scholar] [CrossRef] [PubMed]
- Zhang, Q.; Saleem, M.; Wang, C. Probiotic strain Stenotrophomonas acidaminiphila BJ1 degrades and reduces chlorothalonil toxicity to soil enzymes, microbial communities and plant roots. AMB Express 2017, 7, 227. [Google Scholar] [CrossRef] [PubMed]
- Hynes, R.K.; Leung, G.C.; Hirkala, D.L.; Nelson, L.M. Isolation, selection, and characterization of beneficial rhizobacteria from pea, lentil, and chickpea grown in western Canada. Can. J. Microbiol. 2008, 54, 248–258. [Google Scholar] [CrossRef] [PubMed]
- Compant, S.; Brader, G.; Muzammil, S.; Sessitsch, A.; Lebrihi, A.; Mathieu, F. Use of beneficial bacteria and their secondary metabolites to control grapevine pathogen diseases. BioControl 2013, 58, 435–455. [Google Scholar] [CrossRef]
- Pineda, A.; Zheng, S.J.; Van Loon, J.J.; Pieterse, C.M.; Dicke, M. Helping plants to deal with insects: The role of beneficial soil-borne microbes. Trends Plant Sci. 2010, 15, 507–514. [Google Scholar] [CrossRef] [PubMed]
- Saleem, M.; Meckes, N.; Pervaiz, Z.H.; Traw, M.B. Microbial interactions in the phyllosphere increase plant performance under herbivore biotic stress. Front. Microbiol. 2017, 8, 41. [Google Scholar] [CrossRef] [PubMed]
- Shen, Z.; Ruan, Y.; Xue, C.; Zhong, S.; Li, R.; Shen, Q. Soils naturally suppressive to banana Fusarium wilt disease harbor unique bacterial communities. Plant Soil 2015, 393, 21–33. [Google Scholar] [CrossRef]
- Jiang, J.; Song, Z.; Yang, X.; Mao, Z.; Nie, X.; Guo, H.; Peng, X. Microbial community analysis of apple rhizosphere around Bohai Gulf. Sci. Rep. 2017, 7, 8918. [Google Scholar] [CrossRef] [PubMed]
- Xiong, W.; Zhao, Q.; Zhao, J.; Xun, W.; Li, R.; Zhang, R.; Wu, H.; Shen, Q. Different continuous cropping spans significantly affect microbial community membership and structure in a vanilla-grown soil as revealed by deep pyrosequencing. Microb. Ecol. 2015, 70, 209–218. [Google Scholar] [CrossRef] [PubMed]
- Velázquez-Becerra, C.; Macías-Rodríguez, L.I.; López-Bucio, J.; Flores-Cortez, I.; Santoyo, G.; Hernández-Soberano, C.; Valencia-Cantero, E. The rhizobacterium Arthrobacter agilis produces dimethylhexadecylamine, a compound that inhibits growth of phytopathogenic fungi in vitro. Protoplasma 2013, 250, 1251–1262. [Google Scholar] [CrossRef] [PubMed]
- Voort, M.; Kempenaar, M.; Driel, M.; Raaijmakers, J.M.; Mendes, R. Impact of soil heat on reassembly of bacterial communities in the rhizosphere microbiome and plant disease suppression. Ecol. Lett. 2016, 19, 375–382. [Google Scholar] [CrossRef] [PubMed]
- Beneduzi, A.; Ambrosini, A.; Passaglia, L.M. Plant growth-promoting rhizobacteria (PGPR): Their potential as antagonists and biocontrol agents. Genet. Mol. Biol. 2012, 35, 1044–1051. [Google Scholar] [CrossRef] [PubMed]
- Grosch, R.; Faltin, F.; Lottmann, J.; Kofoet, A.; Berg, G. Effectiveness of 3 antagonistic bacterial isolates to control Rhizoctonia solani Kühn on lettuce and potato. Can. J. Microbiol. 2005, 51, 345–353. [Google Scholar] [CrossRef] [PubMed]
- Zhang, N.; Wu, K.; He, X.; Li, S.Q.; Zhang, Z.H.; Shen, B.; Yang, X.M.; Zhang, R.F.; Huang, Q.W.; Shen, Q.-R. A new bioorganic fertilizer can effectively control banana wilt by strong colonization with Bacillus subtilis N11. Plant Soil 2011, 344, 87–97. [Google Scholar] [CrossRef]
- Beckers, B.; De Beeck, M.O.; Thijs, S.; Truyens, S.; Weyens, N.; Boerjan, W.; Vangronsveld, J. Performance of 16s rDNA primer pairs in the study of rhizosphere and endosphere bacterial microbiomes in metabarcoding studies. Front. Microbiol. 2016, 7, 650. [Google Scholar] [CrossRef] [PubMed]
- Fast Length Adjustment of SHort Reads. Available online: http://ccb.jhu.edu/software/FLASH/ (accessed on 4 August 2013).
- GreenGene Database. Available online: http://greengenes.lbl.gov/Download/ (accessed on 1 March 2016).
- DeSantis, T.Z.; Hugenholtz, P.; Larsen, N.; Rojas, M.; Brodie, E.L.; Keller, K.; Huber, T.; Dalevi, D.; Hu, P.; Andersen, G.L. Greengenes, a chimera-checked 16S rRNA gene database and workbench compatible with ARB. Appl. Environ. Microbiol. 2006, 72, 5069–5072. [Google Scholar] [CrossRef] [PubMed]
- Caporaso, J.G.; Kuczynski, J.; Stombaugh, J.; Bittinger, K.; Bushman, F.D.; Costello, E.K.; Fierer, N.; Peña, A.G.; Goodrich, J.K.; Gordon, J.I.; et al. QIIME allows analysis of high-throughput community sequencing data. Nat. Methods 2010, 7, 335–336. [Google Scholar] [CrossRef] [PubMed]
- Bennett, L.T.; Kasel, S.; Tibbits, J. Non-parametric multivariate comparisons of soil fungal composition: Sensitivity to thresholds and indications of structural redundancy in T-RFLP data. Soil Biol. Biochem. 2008, 40, 1601–1611. [Google Scholar] [CrossRef]
- Huang, Y.E.; Wang, Y.; He, Y.; Ji, Y.; Wang, L.P.; Sheng, H.F.; Zhang, M.; Huang, Q.T.; Zhang, D.J.; Wu, J.J.; et al. Homogeneity of the vaginal microbiome at the cervix, posterior fornix, and vaginal canal in pregnant Chinese women. Microb. Ecol. 2015, 69, 407–414. [Google Scholar] [CrossRef] [PubMed]
- Krueger, C.L.; Sheikh, W. A new selective medium for isolating Pseudomonas spp. from water. Appl. Environ. Microbiol. 1987, 53, 895–897. [Google Scholar] [PubMed]
- Ahmad, F.; Ahmad, I.; Khan, M.S. Screening of free-living rhizospheric bacteria for their multiple plant growth promoting activities. Microbiol. Res. 2008, 163, 173–181. [Google Scholar] [CrossRef] [PubMed]

| Categories | Observed Species | Chao1 | ACE | Shannon |
|---|---|---|---|---|
| Rhizosphere | ||||
| NPR | 495.7 c | 566.4 c | 593.7 b | 5.042 c |
| MUR | 654.7 a | 718.5 a | 742.5 a | 5.675 a |
| MIR | 555.3 b | 628.3 b | 651.9 b | 5.493 b |
| Rhizoplane | ||||
| NPP | 575.0 b | 634.3 a | 652.6 ab | 5.735 a |
| MUP | 696.3 a | 755.9 a | 766.7 a | 5.975 a |
| MIP | 431.7 c | 615.6 a | 565.8 b | 2.496 b |
| Pairwise Comparison | R2 | p-Value * |
|---|---|---|
| Rhizosphere | ||
| NPR-MUR | 0.9778 | 0.1000 |
| NPR-MIR | 0.9735 | 0.0014 |
| MUR-MIR | 0.9340 | 0.0014 |
| Rhizoplane | ||
| NPP-MUP | 0.9158 | 0.1000 |
| NPP-MIP | 0.9867 | 0.0014 |
| MUP-MIP | 0.9929 | 0.0083 |
| Rhizosphere vs. rhizoplane | ||
| NPR-NPP | 0.9580 | 0.0014 |
| MUR-MUP | 0.9276 | 0.0014 |
| MIR-MIP | 0.9913 | 0.0417 |
© 2018 by the authors. Licensee MDPI, Basel, Switzerland. This article is an open access article distributed under the terms and conditions of the Creative Commons Attribution (CC BY) license (http://creativecommons.org/licenses/by/4.0/).
Share and Cite
Wu, L.; Chen, J.; Xiao, Z.; Zhu, X.; Wang, J.; Wu, H.; Wu, Y.; Zhang, Z.; Lin, W. Barcoded Pyrosequencing Reveals a Shift in the Bacterial Community in the Rhizosphere and Rhizoplane of Rehmannia glutinosa under Consecutive Monoculture. Int. J. Mol. Sci. 2018, 19, 850. https://doi.org/10.3390/ijms19030850
Wu L, Chen J, Xiao Z, Zhu X, Wang J, Wu H, Wu Y, Zhang Z, Lin W. Barcoded Pyrosequencing Reveals a Shift in the Bacterial Community in the Rhizosphere and Rhizoplane of Rehmannia glutinosa under Consecutive Monoculture. International Journal of Molecular Sciences. 2018; 19(3):850. https://doi.org/10.3390/ijms19030850
Chicago/Turabian StyleWu, Linkun, Jun Chen, Zhigang Xiao, Xiaocheng Zhu, Juanying Wang, Hongmiao Wu, Yanhong Wu, Zhongyi Zhang, and Wenxiong Lin. 2018. "Barcoded Pyrosequencing Reveals a Shift in the Bacterial Community in the Rhizosphere and Rhizoplane of Rehmannia glutinosa under Consecutive Monoculture" International Journal of Molecular Sciences 19, no. 3: 850. https://doi.org/10.3390/ijms19030850
APA StyleWu, L., Chen, J., Xiao, Z., Zhu, X., Wang, J., Wu, H., Wu, Y., Zhang, Z., & Lin, W. (2018). Barcoded Pyrosequencing Reveals a Shift in the Bacterial Community in the Rhizosphere and Rhizoplane of Rehmannia glutinosa under Consecutive Monoculture. International Journal of Molecular Sciences, 19(3), 850. https://doi.org/10.3390/ijms19030850

